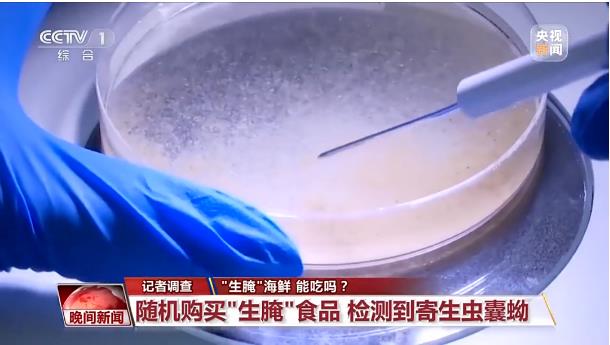

??? ??? ?, ???, ??? ? '??' ???? ??? ??? ??? ?? ??. ??? ‘??’ ????? ???, ??, ? ? ????? ????? ?, ??, ?? ? ??? ?? ?? ?? ??? ??? ?? ???. ?? ?? ??? ?? ????? ?? ???? ???? ???? ??? ??? ?? ?? ???? ??. '??' ???? ??? ??? ??, ?? ?? ??? ? ???? ?? ? ???? ?? ??? ?? ? ? ?? ??? ??? ??? ??.
??? ?? 1: ?????? ?????? ? ??????? ????????, ???, ?????? ?? ?? ?? ?? ? ???? ?? ?????? ?? ???? ??. ?? ????? ??????? ??? ??? ????. ??? ??? ???? ??? ???? ??? ???? ???? ??? ????? ??.
??? ?????????? ???? ??:
???? ????? ???? ???, ??? ????? ?? ???? ????(?????)? ?? ?? ? ? ??.
???? ?????(華支睪吸蟲)??? ??? ?? ????? ?? ?? ? ? ?? ??? ?????. ???? ??? ???? ??? ??? ??? ??, ??? ??? ???, ???, ??? ?? ??? ? ??. ?? ????? ?????? ?????? ????? ???? ?? ??? ??? ????? ????.
?????? ???????? ???? ???? ???:
?????(華支睪吸蟲)? ?? ?? ???? ?????? ??? ?? ?? ?? ?? ????? ???, ??? ??? ?? ??. ?????? ??? ? ?? ??? ??? 5? ??, ?? 4.5~6.1? ????.
??? ?? 2: ??? ?? ??? ?? ? ??? ??? ??? ??? ??, ?? ? ??? ?? ? ???? ?? ? ??? ???.
?????? ???????? ???? ???? ???:
?? ???? ?, ??? ?? ??? ??? ????? ????? ???? ?? ??? ???? ???? ? ??? ???? ??? ?? ???? ???? ???. ?? ??? ?? ??? ??? ??? ??? ?? ??? ??, ?? ?? ??, ??, ??? ??? ???? ??? ‘??’ ??? ??? ??? ?? ??? ?? ??.